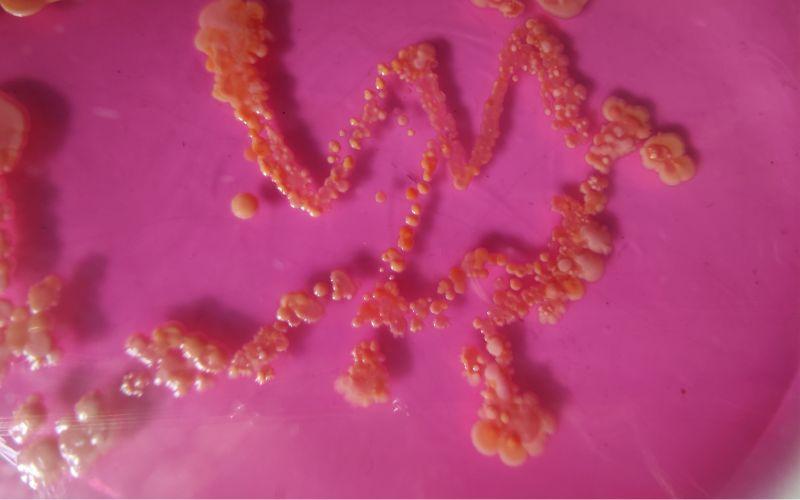

¿Qué son las bacterias aerobias?
Las bacterias aerobias son un amplio grupo de microorganismos que se caracterizan porque necesitan del oxígeno para sus procesos metabólicos. Estas bacterias emplean el oxígeno para degradar compuestos orgánicos hasta compuestos más sencillos a través de un proceso que se conoce como respiración celular.
Muchos especialistas sostienen que la aparición de este tipo de bacterias es consecuencia directa del proceso de fotosíntesis. Debido a este, los niveles de oxígeno atmosférico se incrementaron y en un principio fueron tóxicos para muchos seres vivientes. A causa de esto, innumerables organismos debieron adaptarse y comenzar a utilizar el oxígeno.
Son muchas las especies que se incluyen dentro de grupo de las bacterias aerobias. Las más representativas son las de los géneros Bacillus, Mycobacterium y Nocardia. De igual forma, muchas de estas bacterias son conocidos agentes patógenos del ser humano, llegando incluso a ocasionar patologías que pueden ocasionar la muerte.
Características de las bacterias aerobias
- Dependencia del oxígeno. Estas bacterias necesitan oxígeno molecular (O2) para llevar a cabo la respiración celular, proceso mediante el cual obtienen energía de los nutrientes. Utilizan el oxígeno para descomponer moléculas orgánicas y generar energía en forma de ATP (adenosín trifosfato).
- Localización en el entorno. Suelen encontrarse en lugares con niveles adecuados de oxígeno, como la superficie de suelos, agua y en tejidos animales y vegetales expuestos al aire.
- Estructura celular. Poseen una membrana celular, pared celular y material genético (ADN). Su estructura celular varía dependiendo de la especie, y pueden presentar diferentes tipos de formas y estructuras, como bacilos (bastón), cocos (redondos) o espirilos (forma de espiral).
- Patogenicidad. Si bien muchas bacterias aerobias son beneficiosas o no causan daño, algunas pueden ser patógenas y causar enfermedades en humanos y otros organismos. Por ejemplo, Mycobacterium tuberculosis es una bacteria aerobia responsable de la tuberculosis en humanos.
- Aplicaciones y beneficios. Algunas bacterias aerobias se utilizan en la industria y la investigación. Por ejemplo, algunas especies de Pseudomonas se emplean en la producción de productos químicos y en la degradación de contaminantes ambientales.
- No sintetizan la catalasa. La mayoría de las especies aerobias no tienen la capacidad de sintetizar la enzima catalasa, por lo que no pueden desdoblar la molécula de peróxido de hidrógeno en agua y oxígeno.
Tipos de bacterias aerobias
De manera general se entiende que las bacterias aeróbicas son aquellas que requieren de la presencia de oxígeno para poder desarrollarse y crecer. Sin embargo, la necesidad de este elemento químico no es igual para todas. En este sentido, existen varios tipos de bacterias aeróbicas: aerobias obligadas, anaerobias facultativas y microaerófilas.
- Bacterias aerobias obligadas. Obligatoriamente requieren del oxígeno para poder desarrollarse y llevar a cabo el proceso de respiración celular.
- Bacterias anaerobias facultativas. Desde el punto de vista evolutivo tienen cierta ventaja, ya que pueden sobrevivir tanto en ambientes donde hay oxígeno, como en aquellos donde no hay. Esto se debe a que dentro de su maquinaria celular, cuentan con los elementos necesarios para realizar procesos anaeróbicos mediante los cuales pueden obtener energía. De manera que, en ausencia de oxígeno, no mueren, sino que realizan otros procesos metabólicos.
- Bacterias microaerófilas. Este es un tipo de bacteria muy particular. Emplean el oxígeno como elemento primordial para ejecutar el proceso de respiración celular. Sin embargo, las concentraciones atmosféricas de este gas (aproximadamente 21%) son tóxicas para estas bacterias.
Especies de bacterias aerobias
Bacterias del género Bacillus
El género Bacillus está conformado por una gran variedad de especies, las cuales se caracterizan por tener forma de bastón y ser grampositivas. Una de las características más destacada de estas bacterias es que cuando las condiciones ambientales se vuelven hostiles, en sus células generan esporas. Estas son muy resistentes y tienen como finalidad garantizar que la bacteria pueda sobrevivir en condiciones ambientales nocivas.
Dentro de este género, hay bacterias aerobias estrictas, y otras consideradas aerobias facultativas. Entre las especies de bacterias del género Bacillus se pueden mencionar: Bacillus anthracis, Bacillus cereus, Bacillus subtilis y Bacillus thuringiensis, entre otras.
Bacillus anthracis
Es una bacteria muy conocida y estudiada, ya que debido a su potencial y evidente patogenicidad, ha sido utilizada como arma biológica. Sus esporas son muy tóxicas y penetran con facilidad en el cuerpo humano, a través del tracto respiratorio por inhalación, mediante la ingestión de alimentos contaminados o por contacto con alguna herida abierta.
Ya en el organismo, ocasiona una infección que, de manera genérica, se conoce con el nombre de ántrax, que puede ser cutáneo, pulmonar o gastrointestinal.
Bacillus cereus
Es una bacteria aerobia facultativa muy conocida por producir toxinas. Estas toxinas pueden ocasionar diversas patologías en el ser humano, como el síndrome emético y el síndrome diarreico, ambos a nivel gastrointestinal. Asimismo, puede afectar otros órganos, como los ojos, en los que puede ocasionar queratitis y endoftalmitis.
Bacillus subtilis
Es quizás la especie más estudiada del género Bacillus, considerada la “especie tipo”. Produce esporas, específicamente endosporas, que se encuentran en el centro de la célula bacteriana.
Es una bacteria inocua para el ser humano, salvo algunos casos muy aislados de intoxicación por alimentos contaminados. Además, conlleva una amplia gama de beneficios, como por ejemplo, la síntesis de sustancias antifúngicas y antibióticas, y también aplicaciones en el área industrial.
Género Nocardia
Es un género de bacterias grampositivas con forma de bacilos. Entre sus características más destacadas se puede mencionar que presentan ramificaciones, muchas en ángulo recto.
De igual forma, estas bacterias constituyen agentes patógenos del ser humano muy conocidos. Particularmente dos de sus especies, Nocardia asteroides y Nocardia brasiliensis, han sido suficientemente estudiados como causantes de la nocardiosis pulmonar y del micetoma actinomicótico, respectivamente.
Género Lactobacillus
Son bacterias grampositivas y aerobias facultativas, tienen forma de bacilo y no producen esporas. Son consideradas, de manera general, inocuas e inofensivas para el ser humano.
Al contrario, son famosas por los beneficios que aportan: contribuyen a la conservación de los alimentos, ayudan a controlar algunas enfermedades (como el cáncer de colon), y forman parte de la síntesis de ciertos compuestos, como las vitaminas del complejo B.
Género Staphylococcus
Tienen forma de coco (redondas) y tienden a formar acúmulos celulares con apariencia de racimo de uvas. Las bacterias de este género se consideran aerobias facultativas.
Muchas de las especies de este género son conocidos agentes patógenos del ser humano. Entre estas, la más virulenta es Staphylococcus aureus, que produce ciertas toxinas: hemolisina, enterotoxina, toxina del síndrome del shock tóxico y la toxina exfoliativa. Esas toxinas causan patologías, como diarrea, colitis pseudomembranosa y síndrome de la piel escaldada.
Diferencia entre bacterias aerobias y anaerobias
Las bacterias anaerobias aparecieron en el planeta mucho antes que las bacterias aerobias. Esto se debe a que en las primeras eras de la vida terrestre, el oxígeno no se encontraba formando parte significativa de la atmósfera, por lo que los seres vivos que existían entonces no lo utilizaban para sus procesos metabólicos.
Posteriormente, conforme fue evolucionando la vida en el planeta y los niveles de los gases atmosféricos se estabilizaron, aparecieron los organismos aerobios, que comenzaron a utilizar al oxígeno como elemento principal en procesos de obtención de energía.
Ahora bien, la diferencia principal entre ambos tipos de bacterias es que las aerobias requieren del oxígeno para poder llevar a cabo diversos procesos celulares, siendo el más característico la respiración celular. A través de este proceso obtienen una gran cantidad de energía.
Las bacterias anaerobias, por el contrario, no emplean el oxígeno para ningún proceso. Incluso, para algunas de ellas, el oxígeno resulta altamente tóxico. Debido a esto, realizan otros procesos para obtener la energía que la célula necesita.
Entre estos procesos se encuentra la fermentación, mediante la cual ocurre la degradación de ciertos compuestos, como los carbohidratos, para obtener otros compuestos orgánicos, como por ejemplo, el ácido láctico.
Otra de las diferencias que pueden mencionarse entre estos dos tipos de bacterias es el hábitat en el que pueden encontrarse. Las bacterias anaerobias suelen encontrarse en lugares en los que hay poco oxígeno, como en el sarro que cubre los dientes, mientras que las bacterias aerobias se desarrollan en hábitats en los que hay suficiente oxígeno, como el suelo.
Cultivo de bacterias aerobias
Cuando se va a realizar un cultivo de bacterias aerobias en el laboratorio, lo primero que se debe tener en cuenta es que este tipo de bacterias requieren de una adecuada cantidad de oxígeno. En este sentido, se sabe que las mismas condiciones atmosféricas son ideales. Sin embargo, hay algunas bacterias a las cuales hay que proporcionarles una aireación extra.
En estos casos, lo que puede hacerse es agitar vigorosamente el matraz o burbujear aire esterilizado al medio. En el caso de que el cultivo sea bastante extenso, lo que se recomienda es que se incremente la exposición del medio a la atmósfera. Esto se logra disponiendo el medio en capas poco profundas.
Con respecto a la composición del medio de cultivo a emplear para las bacterias aerobias, va a depender de la especie bacteriana que se esté cultivando. Por ejemplo, para cultivar Staphylococcus aureus, los medios de cultivo que se utilizan con mayor frecuencia son agar sangre al 5%, agar soya tripticasa y caldo BHI infusión cerebro corazón. Las bacterias del género Bacillus también se cultivan de manera exitosa en los medios de cultivo ya mencionados.
Es importante destacar que el caldo BHI infusión cerebro corazón es mundialmente recomendado para el cultivo de bacterias aerobias. En su composición se encuentra infusión de cerebro de ternero e infusión de corazón vacuno, así como peptona, cloruro de sodio y glucosa, entre otros componentes.
Métodos para la cuenta en placa
La cuenta en placa es un procedimiento estándar que se hace en los laboratorios con la finalidad de alcanzar un número aproximado de las bacterias que conforman un cultivo en específico.
Esta técnica tiene su basamento en el conteo de las llamadas unidades formadoras de colonias y permite obtener un número aproximado de bacterias. Es importante destacar que este procedimiento debe ejecutarse con la minuciosidad y rigurosidad que se requiere, ya que cualquier error, por mínimo que sea, puede afectar en gran medida los resultados.
Son varias las técnicas que pueden aplicarse para realizar la cuenta en placa. Aquí se explicarán dos de ellos.
Técnica de vertido en la placa
Primero, hay que preparar el medio de cultivo ideal para el tipo de bacteria que se desea cultivar. Posteriormente, en un área despejada y limpia, se procede a ubicar las cajas de Petri en las que se va a colocar el cultivo.
En cada cápsula de Petri se debe agregar 1 mL de la dilución correspondiente, y unos 20 mL del medio de cultivo que se encuentra fundido. Tras esto, realizar movimientos con la placa de Petri de la siguiente manera: 6 de derecha a izquierda, 6 en sentido a las agujas del reloj, 6 en contra de las manecillas del reloj, y 6 de atrás hacia adelante. Finalmente se espera que el medio se solidifique.
Las cápsulas de Petri se incuban en condiciones de temperatura adecuadas (37 °C) por espacio de 24-48 horas. Una vez transcurrido este tiempo, se debe contabilizar el número de colonias que se desarrollaron.
Técnica de extensión superficial en la placa
Para realizar el conteo a través de esta técnica, se deben colocar las cápsulas de Petri con el medio de cultivo sobre la mesa de manera ordenada para evitar errores. Seguidamente, se inocula 1 mL de cada dilución en cada cápsula.
Asimismo, con ayuda de una varilla de vidrio, extender de manera homogénea el inóculo por toda la superficie del medio de cultivo. Esto debe hacerse a través de movimientos giratorios.
Una vez el inóculo ha sido absorbido por el medio de cultivo, se procede a incubar las cápsulas el tiempo que sea requerido de acuerdo al microorganismo cultivado. Finalmente se deben contar todas las colonias que se hayan desarrollado en las placas seleccionadas.
Patologías causadas por bacterias aerobias
Algunos de los géneros que integran este grupo son conocidos por causar enfermedades en los seres humanos. A continuación se nombran algunas de esas enfermedades con sus respectivos síntomas y tratamientos.
Nocardiosis
La nocardiosis es una enfermedad que puede presentarse de forma aguda o crónica. De acuerdo a los casos clínicos estudiados, la mayoría de las veces se presenta con la sintomatología de una neumonía. Sin embargo, en ocasiones, más que infectar las vías respiratorias, puede afectar la piel directamente, ocasionando lesiones características.
Los síntomas que se observan en la nocardiosis pulmonar son:
- Fiebre elevada.
- Tos crómica que no se alivia con nada.
- Dificultad para respirar.
- Malestar general.
Por otra parte, cuando las bacterias del género Nocardia invaden la piel, puede generarse lo que se conoce como actinomicetoma. Es una infección de tipo granulomatosa y crónica, muy rara, y se presenta usualmente en personas con el sistema inmunológico deprimido. Entre sus síntomas están:
- Fiebre.
- Lesión nodular que presenta una pústula central por la cual puede haber drenado material sanguinolento.
- Absceso cutáneo o subcutáneo.
- Malestar generalizado.
Ántrax
Es el nombre que reciben las infecciones ocasionadas por la bacteria Bacillus anthracis. Es ocasionado por el contacto directo con las esporas de dicha bacteria. El ántrax puede afectar a nivel pulmonar y cutáneo. La pulmonar es la más peligrosa, con una tasa de mortalidad mayor al 90%.
Hace unos años, esta bacteria se hizo famosa porque se estuvieron enviando sobres que contenían esporas, que afectaron en gran medida a quienes los recibieron, ocasionándoles la muerte.
En un principio, los síntomas del ántrax a nivel pulmonar se asemejan a los de un resfriado, sin embargo, conforme pasa el tiempo, evolucionan hasta un cuadro clínico más comprometido, y aparecen:
- Fiebre persistente.
- Dificultad para respirar.
- Incremento de la frecuencia cardiaca.
Eventualmente el paciente empeora y se produce un shock séptico, tras lo cual muere, en la mayoría de los casos.
En lo referente al ántrax cutáneo, el primer signo es una lesión similar a la picadura de un mosquito, que se convierte en crónica y evoluciona hasta convertirse en una escara necrótica.
Hay elevación de la temperatura corporal y malestar general. Es frecuente que este cuadro clínico se resuelva favorablemente, dejando solamente una cicatriz. Sin embargo, no es prudente descuidarse, ya que puede extenderse y ocasionar una bacteriemia.
Tuberculosis
Es una patología que afecta al tracto respiratorio, causada por una bacteria aerobia estricta, la Mycobacterium tuberculosis. Las bacterias se encuentran en las secreciones de quienes padecen la enfermedad, específicamente en la que expulsan cuando tosen. El contacto con esas secreciones es la vía más común de contagio.
Los síntomas de la tuberculosis son:
- Tos constante con expectoración sanguinolenta.
- Fiebre.
- Malestar general.
- Dolor en el pecho, especialmente al toser y al respirar.
- Sudoración profusa durante la noche.
Lepra
Es una enfermedad muy conocida, causada por otra bacteria del género Mycobacterium, la Mycobacterium leprae. Esta es una enfermedad que desde hace siglos ha constituido un flagelo, ya que quienes la padecían eran execrados de la sociedad y obligados a vivir aparte.
Los síntomas más comunes de la lepra son:
- Lesiones de color claro en la piel.
- Protuberancias o nódulos en la piel.
- Pérdida de sensibilidad en ciertas zonas.
- Engrosamiento de la piel.
Con el tiempo, el cuadro clínico empeora, ocasionando que el individuo pierda la funcionalidad de sus miembros superiores e inferiores, desfiguración ocasionada por las lesiones cutáneas y malestares a nivel cutáneo, como sensación constante de ardor en la piel.
Referencias
- Camacho, A., Giles, M., Ortegón, M., Palao, M., Serrano, B. y Velásquez, O. Técnicas para el análisis microbiológico de alimentos. UNAM México 2da edición.
- Dorronsoro, I. y Torroba L. Microbiología de la Tuberculosis. Anales del Sistema Sanitario de Navarra.
- González, P. y Cona, E. Nocardia asteroides. Revista chilena de infectología.
- Hernández, P., Mayorga, J. y Pérez, E. Actinomicetoma por Nocardia brasiliensis. Anales de pediatría.
- Ryan, K. y Ray, C. Sherris Medical Microbiology. Mc Graw Hill. 4th edition.